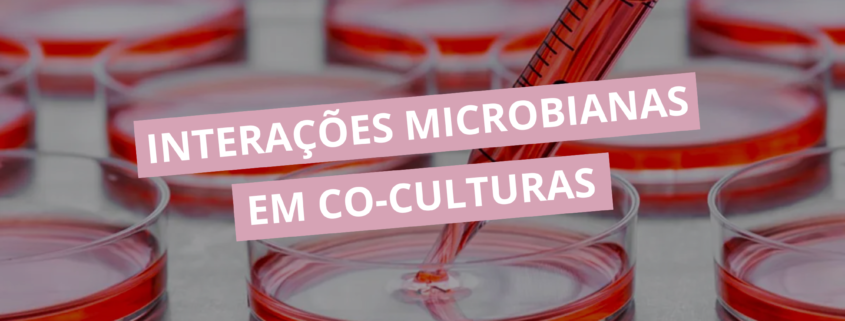

Interações Microbianas em Co-culturas
As interações microbianas em co-culturas representam um dos campos mais fascinantes da microbiologia moderna. Diferente do estudo de microrganismos isolados, a co-cultura permite observar como diferentes espécies interagem em um ambiente controlado, revelando comportamentos como competição, cooperação e produção de metabólitos secundários.
Estas análises são essenciais para compreender ecossistemas microbianos complexos, otimizar processos industriais, descobrir novos compostos bioativos e avaliar efeitos ambientais ou clínicos de comunidades microbianas.
O que são co-culturas microbianas?
Co-culturas consistem na manutenção de duas ou mais espécies microbianas juntas em um mesmo sistema de cultivo, permitindo que interajam de maneira direta ou indireta. Esse método possibilita o estudo de fenômenos que não ocorrem em monoculturas, como:
- Sinergismo: espécies que se beneficiam mutuamente, promovendo crescimento ou sobrevivência.
- Antagonismo: produção de substâncias que inibem outras espécies.
- Comunicação química: troca de sinais moleculares, como quorum sensing, que regula comportamento coletivo.
Tipos de interações em co-culturas
Mutualismo
- Ambas as espécies obtêm benefícios.
- Exemplo: uma bactéria fornece nutrientes que a outra não consegue sintetizar.
Comensalismo
- Uma espécie se beneficia sem prejudicar a outra.
- Importante para estudos ecológicos e ambientais.
Competição
- Organismos competem por nutrientes ou espaço, podendo levar à inibição de uma das espécies.
Amensalismo
- Uma espécie libera compostos tóxicos que prejudicam a outra, sem se beneficiar diretamente.
- Observado na produção de antibióticos naturais.
Aplicações de co-culturas
O estudo de co-culturas microbianas possui diversas aplicações práticas e científicas:
Descoberta de novos antibióticos e metabólitos:
- Microrganismos em co-cultura podem ativar genes silenciosos, produzindo compostos bioativos que não aparecem em monoculturas.
Modelos de ecossistemas microbianos:
- Permite simular interações naturais em solos, água e microbiomas, contribuindo para pesquisas ambientais.
Indústria alimentícia e farmacêutica:
- Otimização de fermentações e produção de enzimas, vitaminas ou produtos químicos.
Estudos de resistência microbiana:
- Avaliação de como a presença de outras espécies influencia tolerância a antibióticos ou estressores ambientais.
Técnicas e metodologias
A manutenção e análise de co-culturas requerem protocolos laboratoriais rigorosos, incluindo:
- Seleção de espécies compatíveis: considerar taxas de crescimento, necessidades nutricionais e tolerância a estressores.
- Controle de ambiente: pH, temperatura, disponibilidade de nutrientes e oxigênio devem ser monitorados.
- Métodos de monitoramento: contagem de células viáveis, microscopia, PCR, sequenciamento e análises de metabólitos.
- Modelos de cultivo: sistemas líquidos, placas de Petri, biorreatores e dispositivos microfluídicos permitem estudo de interações em diferentes escalas.
Desafios das co-culturas
Apesar do potencial, co-culturas apresentam desafios complexos:
- Diferenças de crescimento entre espécies podem causar dominância de uma sobre a outra.
- Controle de contaminação é crítico, especialmente em sistemas mais longos ou em biorreatores.
- A interpretação de interações químicas pode ser complicada, exigindo análises moleculares avançadas.
As interações microbianas em co-culturas abrem portas para o entendimento profundo de ecossistemas microbianos, descoberta de novos compostos e otimização de processos industriais e laboratoriais. Estudar microrganismos juntos, em vez de isolados, revela comportamentos únicos e fenômenos que não poderiam ser observados de outra forma, tornando essa abordagem fundamental para a microbiologia moderna.
Aprofunde seu conhecimento em Microbiologia Clínica! Descubra técnicas avançadas de análise laboratorial, identificação de patógenos e interpretação de exames que fazem a diferença em investigações clínicas. Inscreva-se agora